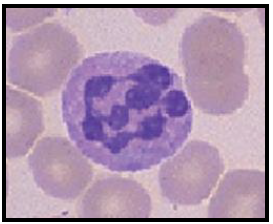
enunciado 540555-1

Foram encontradas 1.167 questões.
Paciente de 44 anos, procedente de Monte
Santo de Minas (MG), morador de zona rural,
sem antecedentes de comorbidades
conhecidas, apresenta-se com queixa de
palpitações taquicárdicas esporádicas. Refere
também dispneia aos esforços (classe
funcional II pela New York Heart Association),
episódios de dor torácica atípica e constipação
intestinal. Apresenta pai com antecedente de
morte súbita aos 42 anos. Ao exame físico não
apresenta alterações significativas. ECG está
demonstrado na figura abaixo.

Em relação ao caso descrito, assinale a alternativa correta quanto à principal hipótese diagnóstica.

Em relação ao caso descrito, assinale a alternativa correta quanto à principal hipótese diagnóstica.
Provas
Questão presente nas seguintes provas
Paciente feminina, de 48 anos, com antecedente
de tabagismo, refere episódio de dor
retroesternal, em aperto, de moderada
intensidade, após realizar esforço (carregar
sacolas de compra), com duração de
aproximadamente 35 minutos. Refere episódios
de dor com as mesmas características há
aproximadamente 1 semana porém de menor
intensidade e duração. Ao exame físico
apresenta frequência cardíaca de 88 bpm,
pressão arterial de 134 x 76 mmHg, ausculta
cardíaca e pulmonar sem alterações e perfusão
preservada. Foi realizado eletrocardiograma que
está representado na figura abaixo.



Quanto à sequência de atendimento mais adequada, assinale a alternativa correta.
Provas
Questão presente nas seguintes provas
Paciente feminina, de 48 anos, com antecedente
de tabagismo, refere episódio de dor
retroesternal, em aperto, de moderada
intensidade, após realizar esforço (carregar
sacolas de compra), com duração de
aproximadamente 35 minutos. Refere episódios
de dor com as mesmas características há
aproximadamente 1 semana porém de menor
intensidade e duração. Ao exame físico
apresenta frequência cardíaca de 88 bpm,
pressão arterial de 134 x 76 mmHg, ausculta
cardíaca e pulmonar sem alterações e perfusão
preservada. Foi realizado eletrocardiograma que
está representado na figura abaixo.

Acerca da conduta imediata mais adequada, assinale a alternativa correta.

Acerca da conduta imediata mais adequada, assinale a alternativa correta.
Provas
Questão presente nas seguintes provas
Paciente do sexo feminino, de 56 anos,
procedente de Cuiabá, refere aparecimento de
lesões isoladas em tronco e membros há 1 ano.
Refere que há 3 meses houve crescimento
progressivo das lesões, com acentuação do
eritema. Nega prurido e episódios de febre.

Quanto aos achados mais prováveis dos exames laboratoriais, assinale a alternativa correta.

Quanto aos achados mais prováveis dos exames laboratoriais, assinale a alternativa correta.
Provas
Questão presente nas seguintes provas
Paciente masculino, de 28 anos, previamente
hígido, admitido na sala de emergência com
queixas de dor torácica associada a dispneia,
palpitações, náuseas e desconforto abdominal que
se iniciaram há cerca de 20 minutos. Relata várias
crises semelhantes nos últimos 12 meses. Os
episódios têm início abrupto, ocorrem sem
nenhum motivo aparente e geralmente remitem
entre 15 ou 20 minutos. Fica muito assustado
durante esses episódios, com a forte impressão de
que algo grave está acontecendo e tem medo de
morrer. Atribui o início dos sintomas ao fato de que
andava muito sobrecarregado no trabalho. Já
procurou diversos médicos e especialistas, sem
que fosse dado um diagnóstico definitivo. Devido
aos sintomas passou a evitar locais de
aglomerações e perdeu oportunidade de promoção
no seu trabalho. Sem alterações no exame físico.
Eletrocardiograma está representado abaixo.

Sobre o diagnóstico mais provável, assinale a alternativa correta.

Sobre o diagnóstico mais provável, assinale a alternativa correta.
Provas
Questão presente nas seguintes provas
Paciente de 34 anos, G3P1A2, no décimo dia de
puerpério, deu entrada no pronto socorro com
queixa de dor torácica associada a dispneia
importante. Ao exame físico apresenta regular
estado geral, corada, hidratada, afebril,
ausculta pulmonar sem alterações, taquipneia
(frequência respiratória de 30 ipm) com
saturação de oxigênio de 84% em ar ambiente,
ausculta cardíaca sem alterações, frequência
cardíaca de 108 bpm e pressão arterial de 86 x
54 mmHg. O eletrocardiograma e o RX de tórax
estão demonstrados nas figuras abaixo. Os
exames laboratoriais demonstram Troponina =
0,9 mcg/dl (Valor normal < 0,01 mcg/dl) e
Peptídeo Natriurético Cerebral (NT pró-BNP) =
1314 pg/dl (Valor normal < 200 pg/dl).

Sobre o diagnóstico mais provável, assinale a alternativa correta.

Sobre o diagnóstico mais provável, assinale a alternativa correta.
Provas
Questão presente nas seguintes provas
Paciente feminina, de 72 anos, queixa-se de
erupção cutânea em glúteo esquerda há 3 dias.
Refere que as lesões foram precedidas por
sensação de dor e queimação local. As lesões
estão representadas na figura abaixo.

Quanto a conduta mais adequada para o tratamento, assinale a alternativa correta.

Quanto a conduta mais adequada para o tratamento, assinale a alternativa correta.
Provas
Questão presente nas seguintes provas
Paciente masculino, 28 anos, procura atendimento
médico devido a quadro de palpitações taquicárdicas.
Refere que o aparecimento foi há 15 minutos, sem
outros sintomas associados. Refere episódios prévios
de palpitações. Ao exame físico apresenta frequência
cardíaca de 184 bpm, pressão arterial de 132 x 76
mmHg, ausculta pulmonar e cardíaca sem alterações,
perfusão preservada. O eletrocardiograma esta
demonstrado na figura abaixo.

O paciente apresentou reversão do ritmo após as medidas realizadas. Novo eletrocardiograma realizado após a reversão encontra-se abaixo.

Quanto ao exame mais indicado para avaliação deste paciente, assinale a alternativa correta.

O paciente apresentou reversão do ritmo após as medidas realizadas. Novo eletrocardiograma realizado após a reversão encontra-se abaixo.

Quanto ao exame mais indicado para avaliação deste paciente, assinale a alternativa correta.
Provas
Questão presente nas seguintes provas
Paciente masculino, 28 anos, procura atendimento
médico devido a quadro de palpitações taquicárdicas.
Refere que o aparecimento foi há 15 minutos, sem
outros sintomas associados. Refere episódios prévios
de palpitações. Ao exame físico apresenta frequência
cardíaca de 184 bpm, pressão arterial de 132 x 76
mmHg, ausculta pulmonar e cardíaca sem alterações,
perfusão preservada. O eletrocardiograma esta
demonstrado na figura abaixo.

Acerca da melhor conduta, assinale a alternativa correta.

Acerca da melhor conduta, assinale a alternativa correta.
Provas
Questão presente nas seguintes provas
Paciente masculino, 44 anos, procura
atendimento com queixa de fraqueza e falta de
ar progressivas há 3 meses. Nas últimas quatro
semanas também notou edema de membros
inferiores e palpitações. Ao exame físico
paciente apresenta-se bastante descorado e
levemente ictérico com parestesia em mãos e
pés; pressão arterial de 115 x 70 mmHg e o
pulso de 94 bpm. O hemograma revelou
hemoglobina de 4,8 g/dL, volume corpuscular
médio de 122 fL, glóbulos brancos de 3.100/mL
com 900 neutrófilos/mL e 2.800 linfócitos/mL,
com linfócitos atípicos, 64.000 plaquetas/mL e
reticulócitos de 0,4%. No esfregaço do sangue
periférico, foram vistas células como a
mostrada na figura abaixo.

Sobre o diagnóstico mais provável, assinale a alternativa correta.
Sobre o diagnóstico mais provável, assinale a alternativa correta.
Provas
Questão presente nas seguintes provas
Cadernos
Caderno Container